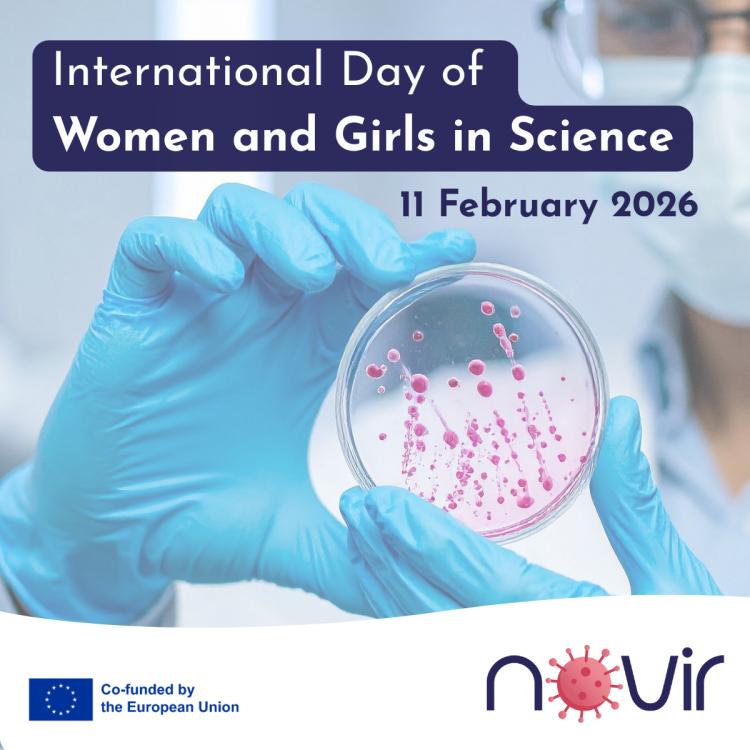

Interviews

Steffen Meyer
Institution Ethris Position NoVir project coordinator
Fostering better protection against infectious diseases lies at the core of Epidemic Preparedness Day. This is a vision shared by the NoVir project, whose team is further developing ETH47, antiviral compound that is protective against multiple viral threats. We spoke with NoVir project coordinator Steffen Meyer (Ethris) about lessons learned from the COVID-19 pandemic, the advantages of transnational collaboration, and the innovative aspects of ETH47.
Fostering better protection against infectious diseases lies at the core of Epidemic Preparedness Day. This is a vision shared by the NoVir project, whose team is further developing ETH47, antiviral compound that is protective against multiple viral threats. We spoke with NoVir project coordinator Steffen Meyer (Ethris) about lessons learned from the COVID-19 pandemic, the advantages of transnational collaboration, and the innovative aspects of ETH47.
In your opinion, what is the most important lesson learned from the COVID-19 pandemic regarding pandemic preparedness?
The most critical lesson is that we need to be prepared before a pandemic strikes, not during it. COVID-19 showed us that developing treatments and vaccines from scratch takes precious time that costs lives. Think of it like having a fire extinguisher at home: you don't want to start shopping for one when your kitchen is already on fire. What became clear is that investing in research and having tools at hand in advance makes all the difference. The reason we could develop COVID vaccines so quickly was because scientists had spent decades working on mRNA technology not specifically for COVID, but as a general platform that could be quickly adapted. Without those years of preparation, we would have been in a far worse situation. We also learned that having strong international cooperation and well-funded public health systems isn't a luxury, it's essential. Viruses don't respect borders, so our response can't be limited by them either.
Why is it important to strengthen not only political but also scientific collaboration at the transnational level to counter epidemic threats?
Imagine trying to solve a huge puzzle when everyone working on it only has access to a few pieces and can't share them. That's what happens when countries work in isolation. Viruses spread globally within days, so our scientific response needs to be equally fast and coordinated. Scientific collaboration across borders brings crucial advantages and prevents "reinventing the wheel." If researchers in one country make a discovery, scientists elsewhere can immediately build on that knowledge. During COVID-19, international collaboration allowed vaccine development at unprecedented speed because teams worldwide shared data in real-time. Partners from different countries also bring different strengths. Some have unmatched expertise in certain fields of research, others have well-established hubs for clinical trials, and others world-class infrastructure for manufacturing. By combining these strengths, we can move from laboratory findings to actual treatments much faster than any single country could alone.
"Viruses spread globally within days, so our scientific response needs to be equally fast and coordinated."
How do the NoVir project and specifically your company contribute to improving the response to epidemic threats?
The NoVir project is driving forward the development of ETH47, a treatment that teaches your body's immune system to be ready for unwanted viral visitors before they can cause trouble. What makes ETH47 valuable for pandemic preparedness is that it could work against virus variants we haven't encountered yet. When a new pandemic virus emerges, we wouldn't have to start from zero. With ETH47 available, we'd have an immediate tool to protect people while scientists develop specific vaccines. Ethris initially developed ETH47, and through the NoVir consortium, we're guiding it through clinical trials. Our partners at the Technical University of Munich and Aarhus University conduct additional laboratory studies, gathering evidence about how well ETH47 works against different viruses.
What makes ETH47 stand out compared to other antiviral drugs?
Most vaccines and conventional antiviral medications work like a very specific key that only fits one lock. They can be very effective, but they only work against viruses they were designed for, and viruses can develop resistance by changing their structure. This means that if the virus changes even slightly, the key doesn't work. ETH47 takes a different approach. Instead of targeting the virus, it activates your body's own built-in antiviral defense system. It delivers instructions (in the form of mRNA) that tell cells in your airways to produce interferon lambda – a natural protein your body normally makes when fighting viral infections. Interferon lambda acts like an alarm system, putting cells into an antiviral state so viruses have much harder time infecting them. Because it's part of your body's natural response, it works against many different respiratory viruses. Whether it's a common cold, a flu variant that jumps from animals to humans, or a completely new coronavirus. Another advantage is that ETH47 works locally, right where you apply it in your nose and airways, concentrating effects exactly where needed while causing minimal effects elsewhere. Traditional antiviral pills travel through your entire bloodstream, sometimes causing side effects in organs that aren't even infected. ETH47's room-temperature stability makes it practical for widespread use, unlike treatments requiring complicated cold storage. The ultimate aim is a self-applied, easy to use product that you could keep in a medicine cabinet like a nasal spray.
To what extent could ETH47 be a game changer for future epidemics?
ETH47 has potential to fundamentally change how we protect people during outbreaks. First, it addresses a major gap: the time it takes to develop specific treatments. ETH47 could be deployed immediately when a new respiratory virus emerges because it strengthens the body's natural defenses that work against many different viruses. Second, ETH47 works at the "front door": the nasal passages and airways where respiratory viruses first enter. By stopping them there, it prevents spread deeper into your lungs. This is especially important for people with chronic lung diseases such as asthma and COPD, whose airways are already sensitive and inflamed. Even a common cold virus can cause a serious flare-up, called an exacerbation, that makes breathing much harder and can become life-threatening. Third, ETH47 is already pretty stable: it can sit at room temperature for more than a week, in the fridge for months, and in a normal freezer for years. That’s a big step up from the early COVID vaccines, which had to be kept super cold and were hard to transport. In parallel with the NoVir project, we are working on spray-dried formulations that allow for even longer storage at room temperature. This makes distribution much easier to remote areas without cold-storage infrastructure. During a pandemic, these logistical advantages could save countless lives. Finally, the NoVir team is investigating how ETH47 works together with existing antivirals, potentially making both more effective.
"ETH47 has the potential to fundamentally change how we protect people during pandemic outbreaks"
The NoVir consortium is conducting both clinical and pre-clinical trials. What is the goal of these different types of studies?
Developing a new medicine is like designing and testing a new airplane before passengers fly on it. Pre-clinical and clinical studies are different testing phases that answer different questions. Pre-clinical studies are laboratory testing – like testing airplane parts in a wind tunnel before building the full aircraft. Scientists use cells and animal models to answer fundamental questions: Does the medicine work as we think? At what dose? Are there harmful effects? This is where our partners at the Technical University of Munich and Aarhus University play a crucial role. They're conducting sophisticated laboratory experiments to understand exactly how ETH47 works against different types of viruses in controlled settings. They're also exploring whether ETH47 could work in combination with other treatments and investigating different ways to deliver it beyond nasal spray. Clinical studies test the medicine in actual human volunteers, like test flights to keep the airplane picture. Phase 1 trials, which ETH47 completed, involve small numbers of healthy volunteers. It focuses on confirming ETH47 is safe and works as expected in people. Phase 2 trials, currently underway at Ethris, test whether the medicine actually helps patients at risk. For ETH47, volunteers with asthma are deliberately exposed to the common cold virus to confirm that ETH47 reduces their symptoms compared to placebo. By combining clinical evidence from real patients with the detailed laboratory insights from our academic partners, we build a complete understanding of how ETH47 can protect people during viral outbreaks.

How has the development of ETH47 advanced, and what challenges remain to be addressed?
ETH47 has made substantial progress. It successfully completed Phase 1 clinical testing, showing it's safe, well-tolerated, and produces interferon lambda in airways as intended. Based on these results, we've now moved into Phase 2 trials where we're testing whether ETH47 actually prevents viral illness in people with asthma who are exposed to rhinovirus. Meanwhile, our consortium partners are advancing the science in parallel. The Technical University of Munich and Aarhus University are conducting laboratory studies that go beyond what we can test clinically right now. They are investigating ETH47’s effectiveness against a broad spectrum of viruses, including respiratory pathogens and viruses transmitted via other routes, exploring its potential to enhance other antiviral treatments in combination settings, and evaluating alternative delivery approaches. This pre-clinical work is essential because it helps us understand ETH47's full potential and prepares us for future clinical trials with different patient groups or virus types. The main challenges ahead involve scaling up our evidence. We need larger Phase 3 trials with thousands of participants to confirm effectiveness across diverse populations before regulatory approval. We also need to determine optimal dosing strategies, i.e. how much, how often, and for how long people should use ETH47 for maximum protection. The NoVir project runs through April 2027, giving us time to complete some of these crucial studies. If everything continues positively, ETH47 could be available within the next few years as a practical tool for pandemic preparedness, backed by both robust clinical evidence and deep scientific understanding of how it works.

Line Reinert
Institution Aarhus University Position Deputy Team Lead
Since 2015, the International Day of Women and Girls in Science has provided an opportunity to recognise the contributions of female researchers, particularly in the natural sciences and technology. One of these inspiring voices is Line Reinert, an Associate Professor in the Department of Biomedicine at Aarhus University and Deputy Team Lead in the NoVir project. In our interview, we talked about her career in molecular medicine and the preclinical studies she is conducting within NoVir.
Since 2015, the International Day of Women and Girls in Science has provided an opportunity to recognise the contributions of female researchers, particularly in the natural sciences and technology. One of these inspiring voices is Line Reinert, an Associate Professor in the Department of Biomedicine at Aarhus University and Deputy Team Lead in the NoVir project. In our interview, we talked about her career in molecular medicine and the preclinical studies she is conducting within NoVir.
You began your academic career in the field of molecular medicine. What fascinated you most about this field?
What fascinated me most about molecular medicine was that it connects the tiniest details of biology to real people’s health. You can look at how a single molecule or a small change in a cell can lead to disease and that understanding can point directly to a solution.
I also loved the feeling that the work is both detective work and teamwork: you ask “how does the disease actually start?” and then use that knowledge to design better ways to prevent or treat illness. That early experience is a big reason why I later focused on immune system and vaccines. Vaccines are one of the most powerful examples of turning basic biology into protection in everyday life.
In what ways are the fields of molecular medicine and virology connected? Could one say that they are complementary to each other?
Molecular medicine and virology are closely connected because they both focus on what happens at a very small scale (inside cells and at the level of genes and proteins). Virology helps us understand how viruses enter cells, hijack the cell’s machinery, and spread. Molecular medicine uses many of the same tools and ways of thinking to understand disease processes and to develop ways to prevent or treat them.
Virology explains the virus side of the story, and molecular medicine helps explain the body’s response and how we can influence that response with treatments or vaccines. When you combine them, you get a much clearer picture of where interventions can work best, from blocking infection early to shaping a strong, lasting immune protection.
In your opinion, what is the main challenge of developing an antiviral that is effective against multiple viral families?
The main challenge is that different viral families can be very different from each other. They don’t all use the same “tools” to copy themselves, and different ways of entering and taking over our cells. So, a drug that works well for one family may simply have nothing to latch onto in another.
To make an antiviral that works broadly, you need to target something that is shared, this could be a host-cell process that viruses commonly exploit or boosting the host immunity. But that comes with a second challenge: you must avoid harming the host’s own cells. So, the balance is finding a target that is common enough to many viruses, but specific and safe enough that you can block infection without causing side effects.
Your team is testing the therapeutic efficiency of ETH47 during viral infection. What will supposedly happen in the body when the drug is used after viral exposure?
After someone has been exposed to a virus, the infection usually starts with a “race” between the virus multiplying and the immune system reacting. ETH47 boosts the immune response to help the body react faster and more effective, so the virus has less time to spread.
Timing matters a lot: used soon after exposure, it may help the immune system get ahead of the virus. Used later, when inflammation is already high, the benefit can be smaller and in some cases, you have to be careful not to push the immune system into an overreaction. That’s why we test not only whether it works, but also when it works best.
ETH47 is also intended as a preventive tool against viral infections. What did you find out so far about the protective effect of the compound?
Previous data showed that ETH47 strengthens the body’s early antiviral defence by priming innate immune responses, helping the immune system react faster and more robustly after exposure to respiratory viruses such as Influenza and SARS-CoV2.
Currently, we are assessing the efficacy against further virus families and delivery routes and in this setting our results suggest that ETH47 can strengthen the body’s early antiviral defence. In our studies, we see signals that it helps the immune system respond faster and stronger after exposure. The rapid response is used to slow viruses down in the first days and milder illness.
What further research activities have you planned within the NoVir project?
We want to test protection against many viruses, to see how broad and robust the effect of ETH47 is across different viral families. We plan to compare and optimize delivery methods in other words, the best way to administer the compound so it provides strong protection and is practical to use for each indication.
In parallel, an important part of our research is to build on our existing understanding of the immune system and deepen the mechanistic picture: which immune cells are doing what, which ones are most important for protection, and how these cells communicate during an infection. This deeper understanding doesn’t just advance the NoVir project, it also provides us with the knowledge needed to design and develop next-generation vaccines and immune-based interventions that can be made available more quickly in the event of a future pandemic.

